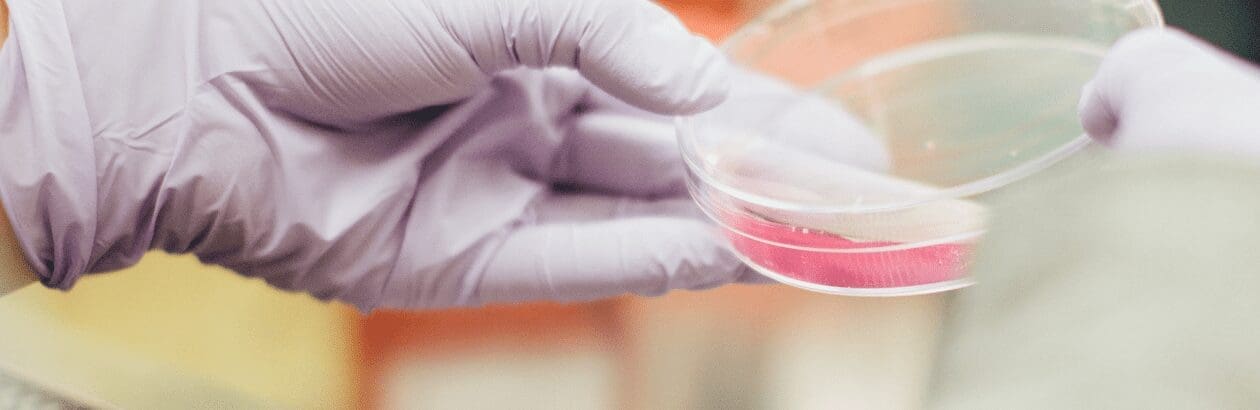

I
In 2011, the social psychologist Daryl Bem published an article claiming that, on the basis of nine experiments with undergraduates, he had found evidence for “psi,” or precognition. According to his data, some students showed the parapsychological ability to guess the rotation and even content of an image they had never seen. The article caused a firestorm in social psychology because it employed practices of research considered rigorous at the time yet it came to a ridiculous conclusion. Upon closer inspection, scholars found that the patterns in his data came from the unconscious product of seemingly innocuous choices he made over the course of his experiments. In other words, the disinterested scientist, searching for the truth, had grasped a lie.
Out of this soul-searching came the open science movement. A diverse coalition of scientists across traditional disciplines, open science supporters want complete transparency into published findings in order to expose sloppy and fraudulent research practices. Proposed reforms include relatively straightforward changes to reporting protocols for academic papers as well as more revolutionary mandates that set new standards for what qualifies as a scientific discovery.
Launched first in social psychology, the movement quickly spread to other social sciences, then the so-called hard sciences, including biology, chemistry, and even astrophysics. Perhaps no other field has faced the brunt of such criticism as psychology, especially after a massive effort to replicate famous experiments found that more than half of published psychology findings fell apart upon closer inspection. For decades, scientists had masked their uncertainty under a mirage of statistical wizardry and poorly defined theories. These stories are not surprising from a theological point of view—humans acting as humans have done since Adam and Eve’s refusal to be held accountable for their corrupted stewardship of the garden of Eden. Yet these revelations clash with the assumptions of many Christian believers about the scientific enterprise.
The time is ripe for a renewed Christian engagement with science, this time not to either defeat it or find acceptance in it, but rather to offer tools that might help redeem it.
Some Christians see science in a similar way to their secular friends: as a mysterious, awe-inducing fount of useful knowledge about human nature and the world. Others treat scientific findings with contempt, assuming that an anti-Christian bias underpins the work of unaccountable technocrats. Both groups, though, subscribe to a view of science as an enterprise, a coherent entity with a mission, be it admirable or damnable. What the open science movement reveals is a far different and uncomfortably familiar story about the foibles of human communities and the difficulty of advancing truth in the midst of personal and institutional injustice. The time is ripe for a renewed Christian engagement with science, this time not to either defeat it or find acceptance in it, but rather to offer tools that might help redeem it. At this crucial juncture, science needs people who hold something more dear than recognition by peers.
The Dark Side of Science
Research fraud and other issues in scientific integrity are nothing new. What has changed in the past ten years is the understanding that the scale of these problems in contemporary science is so large that it questions the very reason for being of the scientific establishment. As members of the growing open science movement have advanced institutional and personal reforms, increased scrutiny continues to uncover a mesmerizing web of scientific malpractice in nearly every field.
For several decades, award-winning Cornell researcher Brian Wansink spent hundreds of thousands of dollars of federal research funds to demonstrate that seemingly inconsequential features of eating establishments, such as the size of bowls used in cafeterias, could affect the amount of food people ate. Wansink’s sloppy research practices were exposed only after he wrote a blog post providing advice to graduate students on how to manipulate data to obtain a desired finding, even if that data set didn’t support the theory. Eventually, after repeated public exposés of his research, Cornell investigated the allegations and then fired him. Given that Wansink’s work influenced the design of federal nutrition programs, his dubious research findings may have had a profound effect on how public schools structured their meal plans and even cafeteria layouts.
Another stunning case involves the Harvard psychology researcher Amy Cuddy, whose bestselling book and TED Talk, with sixty-seven million views and counting, publicized the idea that adopting aggressive “power poses” for a few minutes could increase self-confidence. Her winsome theory, though, depended on a small study she did with undergraduate students, which after closer examination likewise turned out to be a statistical fluke, equivalent to catching a lucky roll of the dice. Multiple replication experiments found no consequential effect of power posing on bodily processes like stress hormones that she had claimed would change if people adopted an aggressive posture. Nonetheless, her fame continues unabated, and an untold number of people walk into bathrooms and adopt a “Wonder Woman” pose before their job interview thanks to her well-publicized yet unsupported theories.
Perhaps the most concerning recent development is that these questionable research practices are not confined to the social sciences. The biologist Elisabeth Bik became a one-woman investigative team when she stumbled on a massive number of duplicated and manipulated images in published articles of cell cultures known as blots. Scanning article after article, she found scientists using image-processing tools like Photoshop to falsely claim that a drug influenced how a cell developed. She gave up her full-time job to devote herself to checking articles, ultimately discovering thousands of forgeries in work that remains ongoing. Some of these forgeries are concerning because they involve areas like cancer research that can have a profound effect on how doctors treat and prescribe patients.
Many other such stories have come out in recent years. Sylvain Lesné, an ambitious Alzheimer’s researcher, influenced the entire trajectory of research into drugs to treat the disease on the basis of images he manipulated in several articles to make his evidence look stronger. Michael LaCour, a political scientist, made up data using sophisticated algorithms to support a widely read study proposing that a short in-person conversation could change people’s attitudes toward the LGBTQ movement. In the past year, Dan Ariely, a behavioural scientist at Duke University with a syndicated column in the Wall Street Journal, has faced credible allegations that he fabricated data from a study showing that if people signed a statement about their car mileage, they would cheat less on insurance claims. Of course, for every discovered article, there remain many more that are undetected, polluting the scientific record with untrustworthy research findings.
Ultimately, the goals of the open science movement are to achieve what many scientists view as their ideals: a transparent and collaborative effort to pursue research that answers important questions about life and the universe. However, investigations into research fraud, which has turned out to be far more rampant than anyone imagined, and resistance to change by important senior scholars have also stirred growing discontent among scientists. Some have opted out of scientific careers, seeing little hope for change. The MeToo movement shone a spotlight on yet another dark side of science’s corrupt institutions as many female junior scholars reported sexual harassment and abuse at the hands of largely unaccountable senior male scientists.
While this movement has attracted some media attention, its revolutionary aspects have remained more or less within the confines of the scientific community. The long-term ramifications of the movement, which sometimes advocates for radical changes like completely open publishing and an abandonment of traditional ways of funding research, are still unclear. Some struggle to see how change is even possible. James Hamblin at The Atlantic, after examining these profound failures, struggles to provide an answer for how science could reform, and even asks his readers to “please tell me if you have the answer.”
To make matters worse for science, all of this uncovering of sloppy and fraudulent research is taking place in a context in which science is jeopardized by increasing political polarization, as the debacles about public health policies during COVID-19 showed. When there are obstacles without, obstacles within, and the perception that cutting corners is the best way to get ahead, it is no wonder that scientists are depressed about . . . science. A recent survey showed that between 5 and 10 percent of scientists admit to falsifying data for studies, and more than half said they had used a knowingly questionable research practice in order to publish a paper.
The Humble Roots of Science
At this point, a hardened science skeptic might sit back, content at having the true nature of science exposed. This type of skepticism drove vaccine non-compliance during the recent pandemic, resulting in hundreds of thousands of needless deaths. Some Christians may be content to watch the whole enterprise burn as just retribution for expounding theories like Darwin’s natural selection that ostensibly undermine core claims of the Christian faith.
Just as David refused to take vengeance against his enemy King Saul, Christians must not take joy in this self-implosion. Science as the foundation of progressive humanism may be in a stage of terminal decline. Even without the revelations of the open science movement, the stark reality that technological progress has brought on a climate catastrophe undermines the belief in science as a cure-all for humanity’s woes. While science does need to let go of triumphalism and elevation of human ego, these two traits are not in fact core to what science is supposed to be.
Much of the contemporary dispute between faith and science dates back to the hubris of Enlightenment philosophers like David Hume, who saw scientific empiricism as evidence of a radical reorientation of human knowledge. With Newton’s laws, we would no longer need to rely on divine revelation for truth, but rather only on our ability to figure things out. This sense of superiority, unsurprisingly, led to beliefs about the supremacy of the white race. If whites had invented science, and science represented an astronomical leap forward, then surely European culture had to be at a higher level of development than others. Darwin’s theory of natural selection gave a quasi-scientific basis for this ethnocentrism.
The racism of much of early twentieth-century science has thankfully faded to the past, although studies of the influence of genetics on human behaviour appear at times to resurrect these bogeymen. Nonetheless, the sense of superiority remains an aura around the scientific community, even if many scientists are themselves practicing religious believers. We should not, of course, be surprised at this—few people will object to being told they have a special purpose that puts them on a higher plane than mere mortals. In a secular society, science seems to hold the significance of a religious denomination, complete with priests (psychotherapists) to mediate between “God” and man.
None of these cultural trappings, though, are either required for or mandated by modern science, so long as we reject the idea that science came about by whites’ genetic superiority. If we go back in time, we can find ample evidence of science in non-Western settings, especially in the medieval Muslim period. Muslim rulers in Baghdad purchased every book they could find, leading to the largest libraries and centres of learning at the time. Much of Western scholarship came about via Muslim scholars’ translations of Greek and Roman texts, as well as Muslims’ own contributions to geometry, algebra, and astronomy. A close look at history shows that if things had turned out differently, the scientific revolution could well have happened in Baghdad rather than Copenhagen.
After decades of being seen as the savior of the premodern world, science must now be rescued from itself.
Some have pointed to Christianity as the reason that the West ultimately became the centre of learning. A more recent examination by Ahmet Kuru, though, suggests otherwise. Analyzing centuries of scientific research in the Abbasid and Ottoman Empires, Kuru shows that Muslim research was just as innovative as their later European intellectual children. Rather, what changed was not Muslims’ proclivity to do research but rather the institutions that supported research. For any science to be successful, it must pursue conclusions irrespective of who holds them, and unfortunately, doing so often has political ramifications. Over time, the rulers of Muslim empires became less tolerant of independent scholars, reducing them to mere vassals of the state.
For these reasons, the miracle of science isn’t due to the high genius of white men in Renaissance-era Europe—despite how self-serving that thought may be to some. Rather, the miracle of science came about because European institutions tolerated conflict between rival thinkers without dissolving into state-backed repression. Many seize on the rift between Galileo and the Roman church over the nature of the solar system as the paradigmatic example of science-religion tensions, but in truth, any scientific advance has had its opponents who would use underhanded means to stop it.
If Christianity played a role in the rise of science, then, it happened by encouraging open institutions and rules to appear: humility, transparency, and a willingness to be proved incorrect. Christian theology did not on its own lead to new scientific advances, nor were Europeans cleverer than Arabs or the Chinese. Instead, European science took on some core attributes of biblical wisdom as it sifted truth from error, leading to a slow but steady accumulation of knowledge. The rest, as they say, is history.
Given this background, it should be clearer why the Christian tradition does have something important to say about contemporary science. At its core, research fraud involves human beings acting in their own selfish interest at the expense of the good of communities who might benefit from research. After decades of being seen as the savior of the premodern world, science must now be rescued from itself.
The Science of the New Creation
Setting science on a sociological basis rather than treating it as a body of immutable truths, as it is so often portrayed, helps reframe the conversation about science and religion. Treating science with deference is not just unnecessary; it harms science in the long run. Emphasizing individual scientists as heroic geniuses perpetuates the myth that the vision of singular people (often men) is responsible for scientific breakthroughs when true discoveries are usually made by loose-knit, collaborative communities working by trial and error.
To make matters worse, the contemporary scientific establishment spends much of its time apportioning prestige, which has become the currency of researchers’ careers. The lucrative prize establishment, including the Nobels, Templetons, Guggenheims, and MacArthurs, recognizes only those who are considered exceptional. Rarely if ever do the givers of awards stop to ask if these scientists have ever admitted to errors, and if so, whether they proved willing to criticize their own work.
A quite different story emerged recently about researcher success that resonated in the open science community. Joana Grave, a postdoctoral researcher in psychology, discovered an error in her data that invalidated both her current work and previous papers. Given that one of the papers had already been published, she could have looked the other way and continued on with her research—it is unlikely anyone would have found the error besides her. Instead, she retracted her published paper, exposing the fact that she made a costly mistake in her data coding. Perhaps even more surprisingly, she wrote an essay describing her experience.
In this case, Grave bore the consequences of the mistake, setting back her emerging career, while science as a discipline reaped the benefits by removing errors from settled findings. Without people willing to put their own interests second, science cannot achieve what it sets out to do. If scientists cannot be trusted to have the integrity to report problems and correct them, even at significant cost to themselves, then any special distinction given to scientific research as a means to discern truth is unmerited.
The open science movement has worked hard to create a new environment in which stories like Grave’s are not considered to be shocking and rare. Some of these reforms involve common-sense practices, such as sharing code and data from research studies and requiring scientists to publish their methodology before undertaking an experiment. However, while these reforms have improved the quality of work in some fields, especially psychology, it is clear that on their own the reforms cannot get to the root of the problem, which lies in the human heart.
So long as scientists are exalted as foresighted geniuses, capable of pulling truth out of nothing, then the Joana Graves of the world will be seen as second-rate scientists at best. People want to believe in a Sherlock Holmes figure who knows things without trying and is absolutely never wrong. This idealized scientist publishes groundbreaking work that changes our understanding of the world while never making a false step.
The scientist must be free of fear for what others might think of their failure. And what is best suited to cast out this fear is love—an absolute, perfect, divine love.
The true genius of science, though, is not in the momentary flashes of inspiration that lead to breakthroughs, as important as these are. Rather, it is the willingness of scientists to question themselves and question each other. Jesus said that “greater love hath no man than this, that a man lay down his life for his friends.” By analogy, no scientist is greater than the one who sacrifices their career to ensure the truth is known. Many open science advocates make these difficult decisions on the basis of their personal values apart from a larger ethical framework. For Christians, though, such choices are a necessary part of the cruciform life that requires the death and ultimate transformation of the ego.
Successful research involves enormous risk. The researcher must invest considerable time and resources pursuing an idea that could end up being wrong. In the ideal model of science—the science, perhaps, of the new creation—each scientist would pursue the most plausible theory regardless of potential risk to themselves. However, to do so, the scientist must be free of fear for what others might think of their failure. And what is best suited to cast out this fear is love—an absolute, perfect, divine love.
Christians are not better scientists than others. Holding correct beliefs about God may save people from certain errors, but it will not grant them superhuman abilities to devise new protein molecules or pathbreaking supercollider experiments. What Christians can and need to bring to the scientific establishment is a firm belief in the fixed reality of God’s love. Christians could play a key role in the realization of the open science movement—not by winning more Nobels but rather by aiming for the noble prize given by the One Prize Committee who sees what is done in secret.